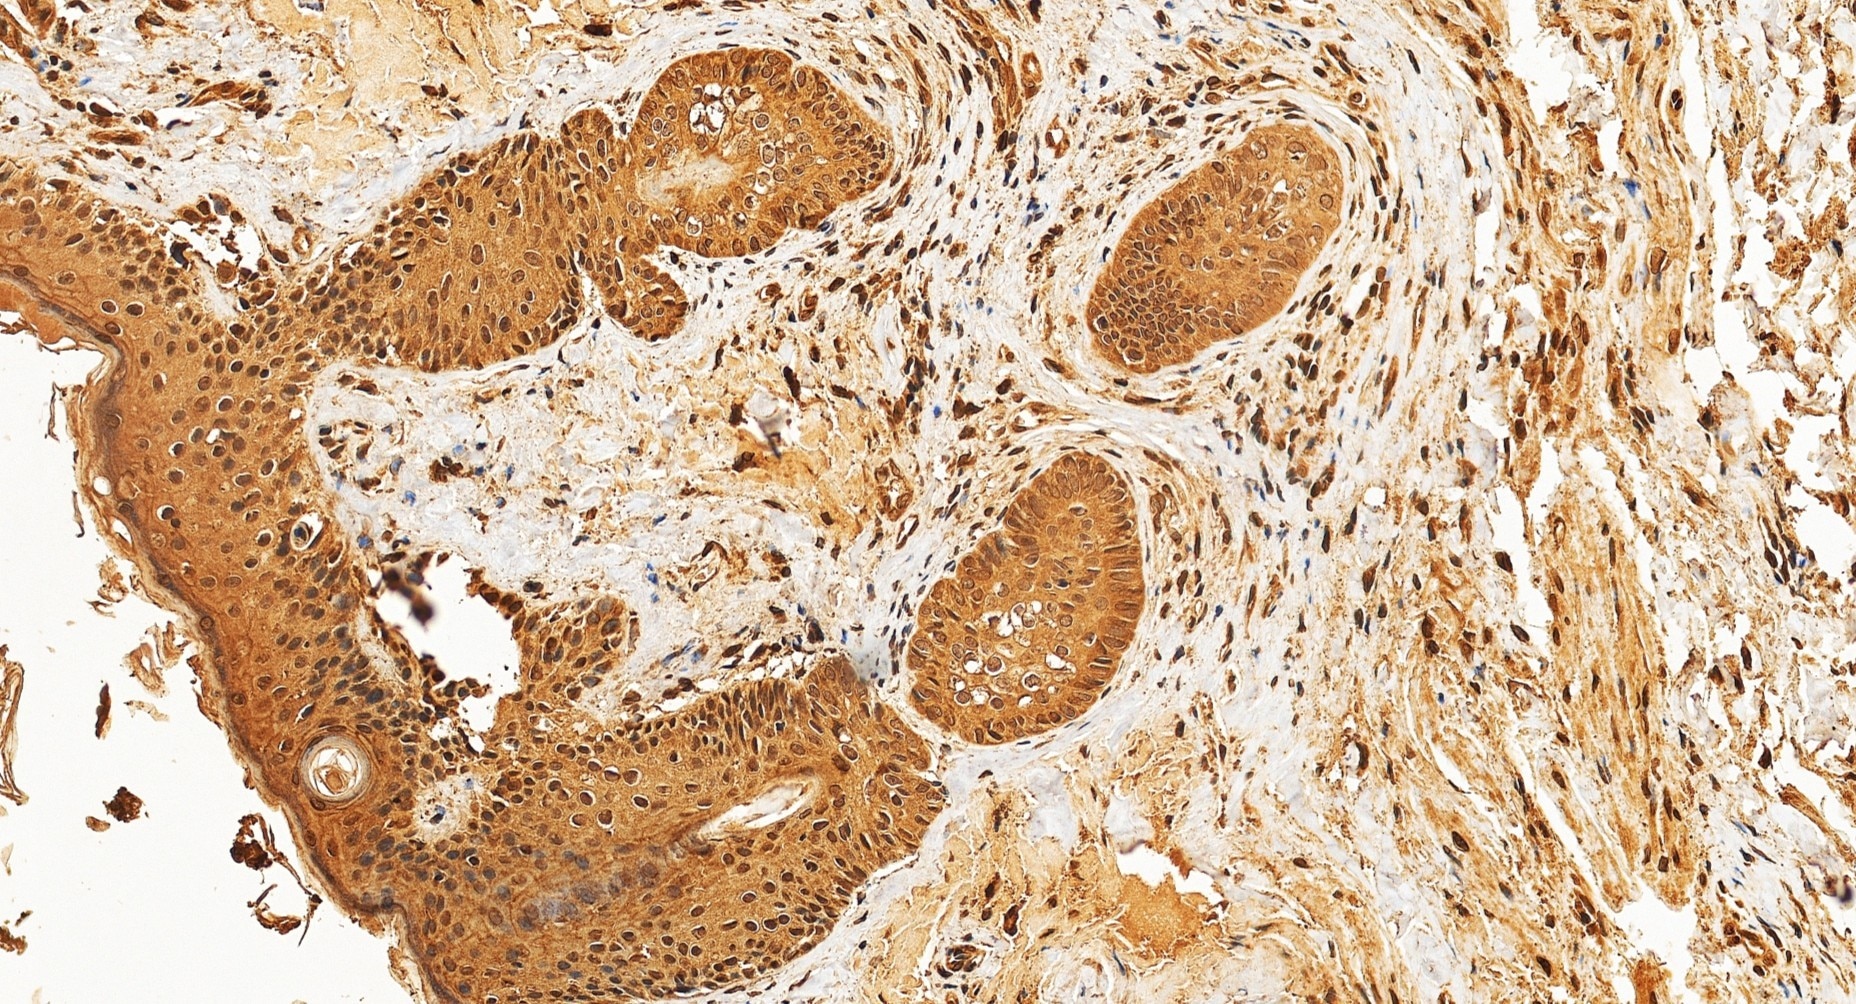
Immunohistochemistry (IHC) staining of human skin squamous cell cancer tissue using Nesprin1/Syne-1 Polyclonal antibody (31095-1-AP)

Tested Applications
| Positive WB detected in | HeLa cells, U2OS cells, mouse brain tissue |
| Positive IHC detected in | human skin squamous cell cancer tissue Note: suggested antigen retrieval with TE buffer pH 9.0; (*) Alternatively, antigen retrieval may be performed with citrate buffer pH 6.0 |
Recommended dilution
| Application | Dilution |
|---|---|
| Western Blot (WB) | WB : 1:1000-1:4000 |
| Immunohistochemistry (IHC) | IHC : 1:200-1:800 |
| It is recommended that this reagent should be titrated in each testing system to obtain optimal results. | |
| Sample-dependent, Check data in validation data gallery. | |
Product Information
31095-1-AP targets Nesprin1/Syne-1 in WB, IHC, ELISA applications and shows reactivity with human, mouse samples.
| Tested Reactivity | human, mouse |
| Host / Isotype | Rabbit / IgG |
| Class | Polyclonal |
| Type | Antibody |
| Immunogen |
CatNo: Ag34809 Product name: Recombinant human SYNE1 protein Source: e coli.-derived, PGEX-4T Tag: GST Domain: 8260-8450 aa of BC039121 Sequence: SLAQPLRSERSGRDTPASVDSIPLEWDHDYDLSRDLESAMSRALPSEDEEGQDDKDFYLRGAVGLSGDHSALESQIRQLGKALDDSRFQIQQTENIIRSKTPTGPELDTSYKGYMKLLGECSSSIDSVKRLEHKLKEEEESLPGFVNLHSTETQTAGVIDRWELLQAQALSKELRMKQNLQKWQQFNSDLN Predict reactive species |
| Full Name | spectrin repeat containing, nuclear envelope 1 |
| Observed Molecular Weight | 120 kDa, 367 kDa, 642 kDa, 1000 kDa |
| GenBank Accession Number | BC039121 |
| Gene Symbol | SYNE1 |
| Gene ID (NCBI) | 23345 |
| Conjugate | Unconjugated |
| Form | Liquid |
| Purification Method | Antigen affinity purification |
| UNIPROT ID | Q8NF91 |
| Storage Buffer | PBS with 0.02% sodium azide and 50% glycerol, pH 7.3. |
| Storage Conditions | Store at -20°C. Stable for one year after shipment. Aliquoting is unnecessary for -20oC storage. 20ul sizes contain 0.1% BSA. |
Background Information
SYNE1, also known as spectrin repeat containing nuclear envelope protein 1. It is expressed in skeletal and smooth muscle, as well as peripheral blood lymphocytes, and localizes to the nuclear membrane. Mutations in the SYNE1 gene have been associated with several diseases, including autosomal recessive spinocerebellar ataxia type 8 (also referred to as autosomal recessive cerebellar ataxia type 1 or recessive ataxia of Beauce) and Emery-Dreifuss muscular dystrophy 4, autosomal dominant. The SYNE1 gene exhibits ubiquitous expression across various tissues, including the ovary and bone marrow. The molecular weight of the SYNE1 protein can vary depending on the specific isoform. For example, the full-length nesprin-1 isoform, also known as nesprin-1 giant, has 8797 amino acids and a molecular weight of approximately 1000 kDa. Another isoform, nesprin-1α2, has a molecular weight of about 120 kDa (PMID: 27782104). The protein has other isoforms with molecular weights of 380 kDa, 167 kDa and 642 kDa respectively.
Protocols
| Product Specific Protocols | |
|---|---|
| IHC protocol for Nesprin1/Syne-1 antibody 31095-1-AP | Download protocol |
| WB protocol for Nesprin1/Syne-1 antibody 31095-1-AP | Download protocol |
| Standard Protocols | |
|---|---|
| Click here to view our Standard Protocols |